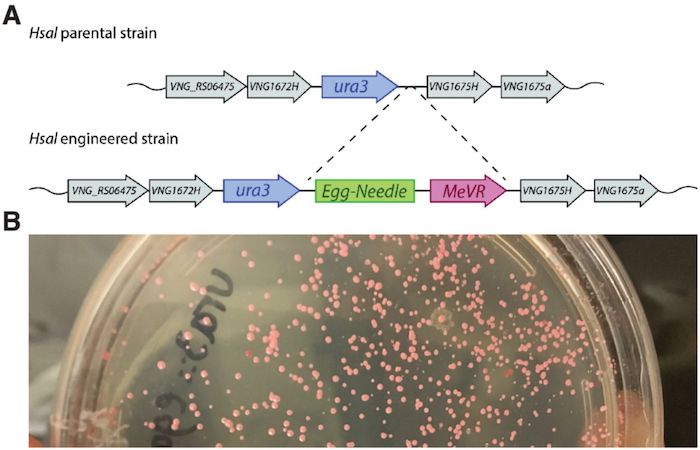

Los científicos encontraron que un microorganismo extremadamente resistente puede guardar información en sus células, incluso después de que estas se hayan copiado múltiples veces.
Ciudad de México, 1 de marzo (RT).- Un grupo de científicos sugiere que el ADN de un microbio que vive en depósitos de sal de roca puede ser utilizado como la cápsula del tiempo perfecta para enviar información a civilizaciones del futuro lejano, de acuerdo con un nuevo estudio publicado recientemente en el servidor de preimpresión para biología bioRxiv.
Los investigadores codificaron la información en el ADN del Halobacterium salinarum, un microbio resistente a la sal y difícil de matar que tiene, de promedio, 25 copias de cada uno de sus cromosomas.
Para preservar un código, los especialistas crearon dos piezas de arte en 3D, que luego fueron reducidas a una cadena de coordenadas y traducidas en códigos base antes de ser insertardas en un lugar del genoma de un H. salinarum. Los científicos observaron que, incluso después de que las células alteradas se hubieran copiado varias veces, el mensaje permanecía estable.

"Si desea conservar datos durante mucho, mucho tiempo, la mejor manera de conseguirlo es mantenerlos dentro de las células y utilizar la maquinaria celular para la reparación automática del ADN. Pueden reproducirse conveniente y económicamente con poca o ninguna intervención", relató el autor principal de la investigación, Joe Davis, a la revista Science.
UN MICROORGANISMO EXTREMADAMENTE RESISTENTE
Investigaciones anteriores exploraron el potencial de almacenamiento del ADN, que contiene el equivalente a aproximadamente 300 megabytes de datos en el núcleo de una célula humana, pero este nuevo estudio combina esa capacidad con la extraordinaria resistencia del Halobacterium salinarum.
Los científicos descubrieron que el microbio puede soportar la sequía, las temperaturas extremas, el vacío prolongado y la radiación intensa. El H. salinarum incluso sobrevivió tras ser expuesto al óxido de etileno, un gas venenoso utilizado para esterilizar equipos de laboratorio.
El microbio tiene un telón de Aquiles: el agua dulce, que revienta sus células, pero cuando el microorganismo está sumergido en bolsas dentro de cristales de sal se convierte en "algo que no puede morir", indica Davis.
Además, el H. salinarum puede preservar el ADN durante mucho más tiempo que las técnicas in vitro, la encapsulación de ADN sintético en vidrio o acero inoxidable, según explicó Davis, quien revivió células del microbio que se encontraban en hibernación en depósitos de sal de cientos de millones de años de antigüedad.
El coautor del estudio, George Church, consideró "totalmente plausible" que las células encontradas en lo profundo de los cristales estables hayan sobrevivido todo este tiempo en un estado latente. El investigador explicó que las células dejan de crecer y su ADN permanece sin cambios, excepto por la degradación gradual, pero cuando lo necesitan pueden "replicarse rápidamente", reparando el daño y generando varias copias.
En el futuro, los científicos planean almacenar estos microbios en sal durante varios años para luego verificar si el código que les han introducido sigue siendo estable.







































![Salinas Pliego amenaza a AMLO: “Le tengo un regalo [...] estoy seguro que le llegará”](https://www.sinembargo.mx/wp-content/uploads/2025/11/salinas-pliego-amenaza-a-amlo1-300x158.jpg?x95190)











